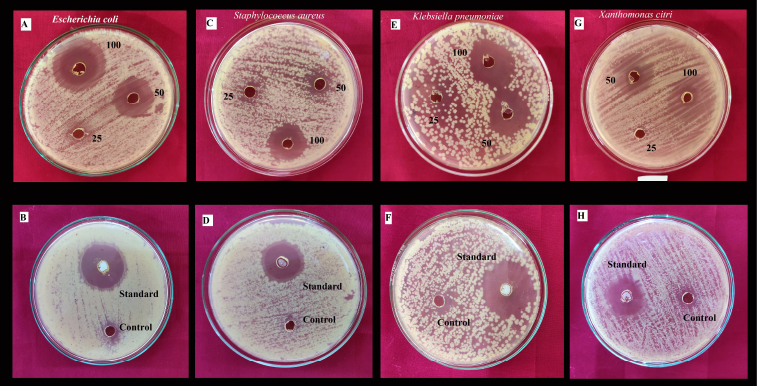

1. INTRODUCTION
The word endophyte is derived from the Greek word “endo” meaning within and “phyte” meaning plants [1]. Endophytes are the microorganisms [2,3] that colonize the living internal tissues of healthy plants, either intercellularly or intracellularly [4], without causing any negative effects or disease symptoms [5,6], and extraordinarily unstudied as potential assets of novel natural merchandise for exploitation in remedy, agriculture, and industries [7,8]. Endophytes are isolated from almost every organ of every plant [9]. The plants are associated with endophytic fungi [10], and are also recognized for their ecological roles influencing host population, plant communities, biosynthesis, biotransformation, and biodegradation [11], and act as biological control agents, enhance plant growth, and promote plants initiation in adverse conditions [12,13]. An intensive search for more recent antimicrobial agents is diagnosing the use of endophytic fungi as novel potential sources of bioactive secondary metabolites, over 25% of prescribed drugs used in human medicine are obtained from fungal endophytes [14].
Fungal endophytes provide a broad variety of bioactive secondary metabolites such as alkaloids, benzapyaranones, flavonoids, phenolic acids, quinones, steroids, terpenoids, tetralones, xanthones [15,16], isocoumarin derivatives, phenols, and peptides [17]. Many fungal endophytes act as the defense systems of the host-plants [18]. These secondary metabolites are known to possess a wide variety of biological activities such as antibiotic, anticancer, antioxidant, anti-inflammatory agents [19,20], antimycotics, immunosuppressants [21], antiviral, and antimicrobial properties [22].
Lobelia nicotianifolia Roth ex Schult. belongs to the family Campanulaceae, commonly known as wild tobacco. The plant has the presence of lobeline, a pyridine alkaloid mainly used for antiepileptic treatment [23]. It is used in numerous ethnobotanical treatments with reported antibiotic, antiseptic [24], anti-inflammatory activities [25], snakebite [26], wounds healing [27], scorpion bite, epilepsy, and the number of respiratory diseases such as asthma, bronchitis, and pneumonia [28]. The study investigates the isolation, identification phylogenetic study, and antibacterial activity of the endophytic fungi Lasidiplodia theobromae on the leaves of L. nicotianifolia from the central Western Ghats region of Chikkamagaluru, Karnataka.
![]() | Figure 1: Map showing the study area of plant collection site, Narashima Parvatha, Kigga, Chikkamagaluru, Karnataka, India. [Click here to view] |
2. MATERIALS AND METHODS
2.1. Study Area and Collection of Samples
Healthy matured leaves of L. nicotianifolia (Fig. 2A) were collected in sterilized polythene bags from the central Western Ghats area of Chikkamagaluru district during December 2020, situated at 13°25′19″N; 75°10′52″E (Fig. 1). The samples were brought to the lab and cultured within 24 hours of collection [29].
2.2. Chemicals and Reagents
The molecular biology chemicals and potato dextrose agar (PDA), from HiMedia Laboratories, dimethyl sulfoxide (DMSO), from Merck Life Science Private Limited, and ethyl acetate, from SDFCL Sd Fine Limited.
2.3. Isolation of Endophytic Fungi
Surface sterilization was carried out by using the method described by Ghimire et al. [30] with slight modifications (95% ethanol for the 30 seconds, 70% ethanol for 5 minutes, and 3% sodium hypochlorite). The surface-sterilized tissues were rinsed three times with sterile water, blot dried, cut into 1 cm2 pieces in aseptic condition, then placed on PDA amended with Amoxicillin and incubation at 25°C ± 2°C, and examined regularly for emerging fungal colonies. The pure cultures were stored on PDA slants at 4°C for later use and 20% glycerol at −20°C for long-term preservation.
2.4. Identification of Endophytic Fungi
2.4.1. Morphological and molecular identification
The pure culture of fungal endophyte was identified based on morphological characteristics [31]. The genomic DNA was extracted from the freshly cultured mycelia using the cetyltrimethylammonium bromide (CTAB) method [32] with modifications. The 5–7–day-old fresh fungal cultures were grown in both liquid broth and culture plates. The fungal mass from the culture plate was scraped out of the mycelium with the help of a spatula. Approximately 300 mg of fungal mycelium was homogenized with 500 μl of 2X CTAB extraction buffer pre-warmed to 65°C in a 1.5 ml microcentrifuge tube with the help of a micropestle, vortexing and incubated in a water bath at 65°C for 1 hour. The centrifugation was for 13,000 rpm for 20 minutes and 1 μl of RNase A added and incubated for 10 minutes at 37°C, and finally Phenol:Chloroform:Isoamyl alcohol (25:24:1) was added with invert mixing. Then it was centrifuged at 10,000 rpm for 10 minutes at room temperature and the supernatant was extracted. To precipitate the DNA, added 500 μl of ice-cold isopropanol and incubated overnight at 4°C, followed by centrifugation at 10,000 rpm for 10 minutes at 4°C to pellet the DNA and washed two times with 70% ethanol, dried and dissolved in 50 μl of 1X TE buffer. 2 μl of genomic DNA was subjected to 0.8% agarose gel electrophoresis and observe under gel doc (BIO-RAD).
![]() | Figure 2: Isolation, culture, and identification of L. theobromae. A. Lobelia nicotianifolia Roth ex Schult. B. Isolation of fungal endophytes C. Pure culture of L. theobromae, D. Reverse side of the colony. E and F. Conidia. Bars = 10 μm. [Click here to view] |
PCR reactions were carried out in 0.2 ml PCR tubes with 50 μl reaction mixture containing, 25 μl double distilled water, 8 μl 10X PCR buffer A. 2.5 μl of each primer, 0.5 μl of Taq DNA polymerase (3 U/μl), 1.5 μl deoxynucleoside triphosphate mixture, and 10 μl of DNA template. The primer pairs ITS 1 and ITS 4 for the ITS region and LROR and LR5 for the LSU region were used. The thermal cycling for ITS amplification was as follows: 4′ 94°C, 32 cycles of 30″ 94°C, 1′ 52°C, 1′ 72°C and a final extension step of 7′ 72°C, for LSU 5′ 94°C, 30 cycles of 30″ 94°C, 1′ 47°C, 1′ 72°C and a final extension step of 7′ 72°C. The PCR products were observed on 1% agarose gel stained with ethidium bromide, under gel image documentation system (Bio-Rad) followed by PCR product purification and sequencing. Both forward and reverse sequences were trimmed using molecular evolutionary genetics analysis (MEGA X) and generated the consensus sequences using Bio Edit and the Basic Local Alignment Search Tool search in the GenBank nucleotide database and both ITS and LSU sequences were deposited to GenBank [33].
![]() | Table 1: List of L. theobrame ITS species, origin, and GenBank accession numbers of the ITS sequences used in phylogenetic analysis. A newly generated sequence is in bold. [Click here to view] |
2.5. Phylogenetic Analysis Maximum Likelihood Method
The molecular phylogenetic examination was conducted by using ITS and LSU sequences independently. The datasets of 15 ITS sequences (Table 1) and 16 LSU sequences (Table 2) were recovered from the National Center for Biotechnology Information (NCBI) GenBank. The multiple sequence alignment was carried out by using the Claustal W and the bootstrap study was examined up to 1,000 replicates. The evolutionary history was inferred by using the Maximum Likelihood method Tamura three-parameter model [34]. Evolutionary analysis was conducted in MEGA X [35].
2.6. Preparation of Fungal Extract
The pure culture of L. theobromae was cultivated in 1,000 ml of potato dextrose broth liquid medium and incubated at 28°C on a shaker at 160 rpm for 4 weeks. The culture filtrate was filtered by vacuum filtration. Afterward, the culture filtrate was extracted with ethyl acetate using a separatory funnel (solvent–solvent extraction). The rotary evaporator with the extract was dried and the crude extract was dissolved in DMSO, and then evaluated for antibacterial activity [36].
2.7. Antibacterial Activity
The antibacterial activity was determined using the agar well diffusion method against three human bacterial pathogens (Escherichia coli, MTCC-1599; Klebsiella pneumoniae, MTCC-7028; and Staphylococcus aureus, MTCC-4734), and one plant pathogen (Xanthomonas campestris, MTCC-228). The crude fungal extract was prepared in DMSO. The 6 mm wells are made by using a sterile borer and loaded with 40 μl of the test sample. The antimicrobial drugs amoxicillin and DMSO were used as positive and negative controls distinctly. The inoculated plates were incubated at 37°C overnight and the zone of inhibition (mm) was recorded [37].
3. RESULTS
3.1. Morphological and Molecular Identification
The colony morphology of the endophytic fungi L. theobromae showed dark gray mycelia, septate, conidia elliptic in shape, curved, and broad septate cells (20.5 × 10.5 μm) (Fig. 2). Molecular identification was carried out by ITS and LSU gene sequencing. The sequences were edited using MEGA X and BIO edit 7.2 software and the consensus sequences were submitted to NCBI GenBank with accession numbers MW858234 and MW876233.
3.1.1. Taxonomy
3.1.1.1. Lasiodiplodia theobromae (Pat.) Griffon & Maubl., Bull. trimest. Soc. Mycol. Fr. 25: 57 (1909). Mycobank 188476.
![]() | Table 2: List of L. theobrame LSU species, origin, and GenBank accession numbers of the ITS sequences used in phylogenetic analysis. A newly generated sequence is in bold. [Click here to view] |
The colony was 4–4.2 cm diameter within 7 days (Fig. 2C), mycelium initially white and become dark, immersed, branched, and septate. Paraphyses hyaline, cylindrical, thin and septate. Conidiomata pycnidial, and the pycnidia was superficial, globose, dark brownish and uninoculated. The conidiophores were absent and conidiogenous cells cylindrical, hyaline, smooth and holoblastic. Conidia (Fig. 2E and F) hyaline with medium septum, dark brown, longitudinal striate and oval shaped measuring 22.5 × 14.5 μm two celled (100X Magnification) using Binocular microscope Lawrence and Mayo.
3.1.1.2. Substrate. Healthy matured leaves of L. nicotianifolia Roth ex Schult.
3.1.1.3. Material examined. India, Karnataka, Kuvempu University, Department of Applied Botany, L. nicotianifolia Roth ex Schult., January 24, 2020, Vinu. K, LS3.
3.2. Phylogenetic Analysis
The phylogenetic evolutionary study was conducted separately for ITS and LSU sequences by NCBI-Blastn, MEGA-X, and Fig Tree software program. The phylogenetic investigation was using the Maximum Likelihood method and Tamura three-parameter model. The trees with the highest log-likelihood for ITS (−1,742.99) and LSU (−955.41) are shown. The difference in Gamma distribution rate between ITS [Type 5 (+G, parameter = 0.4515) and LSU Type 5 (+G, parameter=0.0575)] sites. There are 849 positions in ITS and 556 positions in the final dataset in LSU. In the evolutionary analysis of ITS (Fig. 3) and LSU (Fig. 4), Botryosphaeria dothidea was selected as the out group with GenBank accession numbers MK178544 and MW981605, respectively.
3.3. Antibacterial Activity
The present investigation revealed that that ethyl acetate extract of L. theobromae showed strong antibacterial activity against E. coli, S. aureus, K. pneumoniae, X. campestris compared to Amoxicillin (Fig. 5). Escherichia coli showed a high zone of inhibition among the tested bacterial strains (Table 3).
4. DISCUSSION
The present study showed that a naturally growing medicinal plant Lobelia nicotianifolia, which is grown in the mountain ranges is a natural niche for various fungal endophytes. The need to look for bioactive compounds with antimicrobial values arises from the evolutionary reaction of microbes to existing antibiotics with the resulting increase in resistance rates [38]. To combine economic value with biodiversity, bioprospecting studies have shown the biotechnological potential of endophytes against a variety of pathogens [39]. Most of the existing studies on the biological activity of L. theobromae metabolites have evaluated their potential phytotoxicity, cytotoxicity, and antibacterial activity [40]. The present study reveals the isolation, molecular characterization (ITS & LSU), phylogenetic analysis, and the production of secondary metabolites from the novel endophytic fungi L. theobromae in L. nicotianifolia. The ethyl acetate extract of the endophytic fungi observed significant antibacterial activity than the standard drug, by showing more inhibition zone against X. campestris when compared to the other selected pathogenic bacteria at 100% concentration level.
![]() | Figure 3: Maximum likelihood tree of ITS sequence data. It illustrates the relationships between L. theobromae (MW858234) with other Lasidiplodia species and Botryosphaeria dothidea selected as an out group. [Click here to view] |
![]() | Figure 4: Maximum likelihood tree of LSU sequence data. It illustrates the relationships between L. theobromae (MW876233) with other Lasidiplodia species and Botryosphaeria dothidea selected as an out group. [Click here to view] |
![]() | Figure 5: The antibacterial activity of the ethyl acetate extract of L. theobromae against pathogenic bacterial strains. A and B. Escherichia coli. C and D. Staphylococcus aureus. E and F. Klebsiella pneumoniae. G and H. Xanthomonas citri. [Click here to view] |
![]() | Table 3: Antibacterial activity of the ethyl acetate extract of L. theobromae against the selected test strains. [Click here to view] |
5. CONCLUSION
Endophytes are a novel and significant microbial resource for showing a wide range of biological activities. The biologically active secondary metabolites produced by endophytes have shown promising potential and benefits for human health and safety. The present study showed that the isolation of endophytic fungi L. theobromae and molecular characterized by ITS and LSU gene sequencing. The consensus sequences were submitted in NCBI GenBank and with accession numbers MK178544 and MW981605. The antibacterial activity of the ethyl acetate extract of L. theobromae showed the effective antibacterial activity against the clinical tested bacteria (E. coli, MTCC-1599), (K. pneumoniae, MTCC-7028), (S. aureus, MTCC-4734), and (X. campestris, MTCC-228).
6. ACKNOWLEDGMENTS
The authors are thankful to the Department of Applied Botany, Kuvempu University, Shankaraghatta, for providing the necessary facility to carry out the research work. This work was financially supported by grants from the BUILDERS-PROJECT Department of Biotechnology, New Delhi, Government of India.
7. CONFLICT OF INTEREST
The authors declare no conflicts of interest.
8. AUTHORS’ CONTRIBUTIONS
All authors made substantial contributions to conception and design, acquisition of data, or analysis and interpretation of data; took part in drafting the article or revising it critically for important intellectual content; agreed to submit to the current journal; gave final approval of the version to be published; and agree to be accountable for all aspects of the work. All the authors are eligible to be an author as per the International Committee of Medical Journal Editors (ICMJE) requirements/guidelines.
FUNDING
There is no funding to report
ETHICAL APPROVALS
This study does not involve experiments on animals or human subjects.
DATA AVAILABILITY
All data generated and analyzed are included within this research article.
PUBLISHER’S NOTE
This journal remains neutral with regard to jurisdictional claims in published institutional affiliation.
REFERENCES
1. Jalgaonwala RE, Mohite BV, Mahajan RT. A review: natural products from plant associated endophytic fungi. J Microbiol Biotechnol Res 2011;1(2):21–32.
2. Pharamat T, Tanapat P, Jittra P, Anthony JSW, Prakitsin S. Antimicrobial and anticancer activities of endophytic fungi from Mitrajyna javanica Koord and Val. Afr J Microbiol Res 2013;7(49):5565–72. CrossRef
3. Vinu K, Krishna V, Himani S, Krishnappa M. Hr-Lcms based mychochemical profiling of endophytic Xylaria adscendens (Fr.) Fr., in Wendlandia thyrsoidea (Roth) Steud. of central Western Ghats. Plant Arch 2021;18(1):109–16.
4. Saikkonen K, Faeth SH, Helander M, Sullivan TJ. Fungal endophytes: a continuum of interactions with host plants. Ann Rev Ecol Syst 1998;29(1):319–43. CrossRef
5. Fisher PJ, Anson AE, Petrini O. Antibiotic activity of some endophytic fungi from ericaceous plants. Bot Helv 1984;94:249–53.
6. Wang LW, Xu BG, Wang JY, Su ZZ, Lin FC, Zhang CL, et al. Bioactive metabolites from Phoma species, an endophytic fungus from the Chinese medicinal plant Arisaema erubescens. Appl Microbiol Biotechnol 2012;93:1231–9. CrossRef
7. Strobel G, Daisy B, Castillo U, Harper J. Natural products from endophytic microorganisms. J Nat Prod 2004;67(2):257–68. CrossRef
8. Passari AK, Mishra VK, Saikia R, Gupta VK, Singh BP. Isolation, abundance and phylogenetic affiliation of endophytic actinomycetes associated with medicinal plants and screening for their in vitro antimicrobial biosynthetic potential. Front Microbiol 2015;6:273. CrossRef
9. Zheng YK, Qiao XG, Miao CP. Diversity, distribution and biotechnological potential of endophytic fungi. Ann Microbiol 2016;66:529–42. CrossRef
10. Putra IP, Rahayu G, Hidayat I. Impact of domestication on the endophytic fungal diversity associated with wild Zingiberaceae at Mount Halimun Salak National Park. HAYATI J Biosci 2015;22(4):157–62. CrossRef
11. Naik SB, Krishnappa M, Krishnamurthy YL. Biodiversity of endophytic fungi from seven herbaceous medicinal plants of Malnad region, Western Ghats, southern India. J Forest Res 2014;25(3):707–11. CrossRef
12. Qin S, Xing K, Jiang J, Xu L, Li W. Biodiversity, bioactive natural products and biotechnological potential of plant-associated endophytic actinobacteria. Appl Microbiol Biotechnol 2011;89:457–73. CrossRef
13. Noriler SA, Savi DC, Aluizio R, Cortes PAM, Possiede YM, Glienke C. Bioprospecting and structure of fungal endophyte communities found in the Brazilian biomes, pantanal, and Cerrado. Front Microbiol 2018;9:1–14. CrossRef
14. Cruz DTEE, Notarte KIR, Apurillo CCS, Tarman K, Bungihan ME. Biomining fungal endophytes from tropical plants and seaweeds for drug discovery. In: Ozturk M, Egamberdieva D, Peši? M (eds.), Biodiversity and biomedicine, Academic Press, Cambridge, MA, pp 51–62, 2020. CrossRef
15. Molina G, Pimentel MR, Bertucci TP, Pastore GM. Application of fungal endophytes in biotechnological processes. Chem Eng Transact 2012;27:289–94.
16. Suryanarayanan TS, Thirunavukkarasu N, Govindarajulu MB, Sasse F, Jansen R, Murali, TS. Fungal endophytes and bioprospecting. Fungal Biol Rev 2009;23(1–2):9–19. CrossRef
17. Basha NS, Yemane K, Ogbaghebriel A, Zenebe M. Isolation and screening of endophytic fungi from Eritrean traditional medicinal plant Terminalia brownii leaves for antimicrobial activity. Int J Green Pharm 2012;6(1):40. CrossRef
18. Jia M, Chen L, Xin HL, Zheng CJ, Rahman K, Han T, et al. A friendly relationship between endophytic fungi and medicinal plants: a systematic review. Front Microbiol 2016;7:906. CrossRef
19. Chow Y, Ting ASY. Endophytic l-asparaginase-producing fungi from plants associated with anticancer properties. J Adv Res 2015;6(6):869–76. CrossRef
20. Lakshmi PJ, Selvi KV. Anticancer potentials of secondary metabolites from endophytes of Barringtonia acutangula and its molecular characterization. Int J Curr Microbiol App Sci 2013;2(2):44–55.
21. Nath A, Raghunatha P, Joshi SR. Diversity and biological activities of endophytic fungi of Emblica officinalis, an ethnomedicinal plant of India. Mycobiology 2012;40(1):8–13. CrossRef
22. Devi NN, Prabakaran JJ, Wahab F. Phytochemical analysis and enzyme analysis of endophytic fungi from Centella asiatica. Asian Pac J Trop Biomed 2012;2(3):S1280–4. CrossRef
23. Kolap RM, Kakade PS, Gacche RN, Zimare SB. Assessment of radical scavenging activity and estimation of EC50 values of various extracts of leaves and roots from Lobelia nicotianifolia Roth. (Wild Tobacco). J Herbs Spices Med Plants 2021:1–22. CrossRef
24. Jegan G, Kamalraj P, Muthuchelian K. Medicinal plants in tropical evergreen forest of Pachakumachi Hill, Cumbum Valley, Western Ghats, India. Ethnobot Leafl 2008;12:254–60.
25. Lava MB, Uday M, Nagaraj B. Synthesis and characterization of gold nanoparticles from Lobelia nicotianifolia Leaf extract and its biological activities. Adv Mater lett 2020;11(3):20031491. CrossRef
26. Prakasha HM, Krishnappa M, Krishnamurthy YL, Poornima SV. Folk medicine of NR Pura taluk in Chikmagalur district of Karnataka. Indian J Tradit Knowl 2010;9(1):55–60.
27. Tamboli AM, Rub RA, Ghosh P, Bodhankar SL. Antiepileptic activity of lobeline isolated from the leaf of Lobelia nicotianifolia and its effect on brain GABA level in mice. Asian Pac J Trop Biomed 2012;2(7):537–42. CrossRef
28. Dhruv P, Bavalatti N, Rajagopala M, Kundal PPG. A review on pharmacognostic and physiochemical study of Lobelia nicotianifolia - a folk herb. Int Res J Pharm 2019;8(11):16–23.
29. Nalini MS, Sunayana N, Prakash HS. Endophytic fungal diversity in medicinal plants of Western Ghats, India. Int J Biodiver 2014;2014:1–9. CrossRef
30. Ghimire SR, Charlton ND, Bell JD, Krishnamurthy YL, Craven KD. Biodiversity of fungal endophyte communities inhabiting switchgrass (Panicum virgatum L.) Growing in the native tallgrass prairie of northern Oklahoma. Fungal Divers 2011;47:19–2. CrossRef
31. Deepthi VC, Sumathi S, Faisal M, Elyas KK. Isolation and identification of endophytic fungi with antimicrobial activities from the leaves of Elaeocarpus sphaericus (gaertn.) K. Schum. and Myristica fragrans Houtt. Int J Pharm Sci Res 2018;9(7):2783–91.
32. Karihikeyan V, Patharajan S, Palani P, Spadaro D. Modified simple protocol for efficient fungal DNA extraction highly suitable for PR based molecular methods. Global J Mol Sci 2010;5(1):37–42.
33. Kantharaja R, Krishnappa M. Morphological and molecular phylogenetic studies on Battarrea phalloides (Agaricales): a new report to Indian mycobiota. J Threat Taxa 2020;12(8):15881–8. CrossRef
34. Tamura K. Estimation of the number of nucleotide substitutions when there are strong transition-transversion and G + C-content biases. Mol Biol Evol 1992;9:678–87.
35. Kumar S, Stecher G, Li M, Knyaz C, Tamura K. MEGA X: molecular evolutionary genetics analysis across computing platforms. Mol Biol Evol 2018;35:1547–9. CrossRef
36. Rustamova N, Gao Y, Zhang Y, Yili A. Biological activity of endophytic fungi from the roots of the medicinal plantvernonia anthelmintica. Microorganisms 2020;8:586. CrossRef
37. Suryavamshi GL, Shivanna MB. Diversity and antibacterial activity of endophytic fungi in Memecylon umbellatum burm. F.- a medicinal plant in the Western Ghats of Karnataka, India. Indian J Ecol 2020;47(1):171–80.
38. Astuti P, Wahyono, Nababan OA. Antimicrobial and cytotoxic activities of endophytic fungi isolated from Piper crocatum Ruiz & Pav. Asian Pac J Trop Biomed 2014;4(2):S592–6. CrossRef
39. Noriler SA, Savi DC, Aluizio R, Cortes PAM, Possiede YM, Glienke C. Bioprospecting and structure of fungal endophyte communities found in the Brazilian biomes, pantanal, and Cerrado. Front Microbiol 2018;9:1–14. CrossRef
40. Salvatore MM, Alves A, Andolfi A. Secondary metabolites of Lasiodiplodia theobromae: distribution, chemical diversity, bioactivity, and implications of their occurrence. Toxins 2020;12(7):457. CrossRef